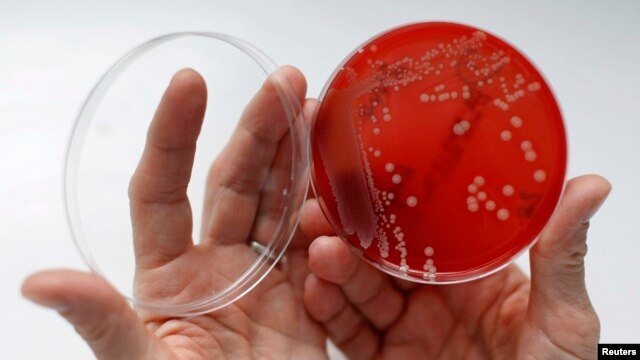
4CAFAAD9-C9A6-4782-8576-0683E18BF79B_w640_r1_s.jpg

Navigation
Install the app
How to install the app on iOS
Follow along with the video below to see how to install our site as a web app on your home screen.
Note: This feature may not be available in some browsers.
More options
Style variation
You are using an out of date browser. It may not display this or other websites correctly.
You should upgrade or use an alternative browser.
You should upgrade or use an alternative browser.
9th century concoction kills MRSA
- Thread starter Gracie
- Start date
Harry Dresden
Only Adamantium Member
Garlic itself is one of natures best antibiotics....
BullKurtz
Gold Member
- Banned
- #4
I enjoy stories like this one....all modern medicine came from synthesized organics. But tell a modern day GP that and they'll look at you with sneer...they're just pill-pushers, afraid of simple procedures. My idiot GP wouldn't even burn a mole off my eyebrow....wanted to send me to a dermatologist! So I bought a bottle of apple cider vinegar and did it myself.....a week of dousing it with the vinegar and covering it wet with a band-aid and it fell off . And I still have the $200 deductible the dermo would have cost me. 

Roadrunner
Roadrunner
Wasn't that interesting.
Old timers here know lots of interesting stuff, like how nettle root tea cures diaherrea (the shits, I never can spell it right).
Roadrunner
Roadrunner
Ma knew some good ones to.I enjoy stories like this one....all modern medicine came from synthesized organics. But tell a modern day GP that and they'll look at you with sneer...they're just pill-pushers, afraid of simple procedures. My idiot GP wouldn't even burn a mole off my eyebrow....wanted to send me to a dermatologist! So I bought a bottle of apple cider vinegar and did it myself.....a week of dousing it with the vinegar and covering it wet with a band-aid and it fell off . And I still have the $200 deductible the dermo would have cost me.
Like a teaspoon of diesel for constipation, or a frogs eye to pull the pus out of a sty.
waltky
Wise ol' monkey
Weakening the pathogen may help antibiotics conquer MRSA...
Antibiotics May Get New Life Against Lethal Bacteria
March 10, 2016 - Antibiotics that have become ineffective against a lethal bacterial infection may get new life, thanks to the discovery of compounds that weaken the pathogen.
Antibiotics May Get New Life Against Lethal Bacteria
March 10, 2016 - Antibiotics that have become ineffective against a lethal bacterial infection may get new life, thanks to the discovery of compounds that weaken the pathogen.
Staphylococcus aureus has become a leading cause of death worldwide. The drugs penicillin and methicillin, developed in the last century, are cheap and available but have become ineffective against the bacterial menace. Newer, more effective antibiotics like vancomycin have been developed, but they are more expensive and have to be given intravenously. So the race is on to develop even more potent antibiotics that are easier to use. But penicillin and methicillin may not be out of the picture. Researchers at pharmaceutical company Merck discovered two compounds that weaken the biological structure of drug-resistant Staph aureus, also known as MRSA, clearing the way for the older antibiotics to kill the pathogen. They describe their work in the journal Science Translational Medicine.

An employee displays MRSA (Methicillin-resistant Staphylococcus aureus) bacteria inside a petri dish containing agar jelly for bacterial culture in a microbiological laboratory in Berlin.
Merck's Terry Roemer said that on their own, the compounds are not effective in killing MRSA. But taken with penicillin, they cleared the drug-resistant infection in mice. “What is different and exciting about this is it is magic dust," Roemer said. "It’s not an antibiotic, but it helps. It’s an adjuvant. It assists.” When the bacterial-weakening compounds become available, possibly in a few years, Roemer said they would be given along with traditional antibiotics to treat drug-resistant bacteria.
More important, Roemer said, the discovery opens up an entirely new avenue of thinking about fighting antibiotic-resistant infections like MRSA. Researchers could employ "more types of chemistry that have never been considered before because those compounds are nonbioactive. I mean, this is something that we need.” Roemer thinks finding ways to boost the effectiveness of existing antibiotics could put scientists ahead in the race to develop new, improved drugs to treat drug-resistant bacterial infections.
Antibiotics May Get New Life Against Lethal Bacteria
waltky
Wise ol' monkey
New weapon against MRSA?...

Extract from Antarctic Sponge Could Open New Front against MRSA
May 18, 2016 - Scientists find natural chemical in creature living in frigid Antarctic waters that could kill increasingly prevalent antibiotic-resistant bacteria

Extract from Antarctic Sponge Could Open New Front against MRSA
May 18, 2016 - Scientists find natural chemical in creature living in frigid Antarctic waters that could kill increasingly prevalent antibiotic-resistant bacteria
A sponge that thrives in frigid Antarctic waters could provide a powerful new weapon against MRSA, a sometimes fatal infection that has become highly resistant to antibiotics. Scientists from the University of South Florida Center for Drug Discovery and Innovation search the world for natural chemicals with pharmaceutical potential. Center director Bill Baker collected samples of a sponge called Dendrilla membranosa from the Southern Ocean. His team extracted a substance they named darwinolide, modified its chemical composition, and tested it against the bacteria that cause MRSA.

A sponge called Dendrilla membranosa is found near Palmer Station, Antarctica, and shows promise against MRSA, a sometimes fatal infection highly resistant to antibiotics.
Writing in the journal Organic Letters, they report that only 1.6 percent of the bacteria survived and grew. MRSA — methicillin-resistant Staphylococcus aureus — was once a serious problem only in health care settings, such as hospitals and nursing homes. But the infection is now found in locker rooms, gyms and schools. It is especially dangerous because it can cause infections almost anywhere in the body, from the skin to the lungs to the lining of the heart. It has developed resistance to the most powerful antibiotics in the medical arsenal.
MRSA bacteria, like many other bacteria, form a biofilm around them as a protective shell. Antibiotics have a hard time penetrating that shell to kill the bacteria inside. Darwinolide appears to attack the biofilm. That, say the researchers, suggests "that darwinolide may present a highly suitable scaffold for the development of urgently needed, novel, anti-biofilm-specific antibiotics."
Extract from Antarctic Sponge Could Open New Front against MRSA
AvgGuyIA
Gold Member
Hmm... Maybe Windex will cure pimples after all.I enjoy stories like this one....all modern medicine came from synthesized organics. But tell a modern day GP that and they'll look at you with sneer...they're just pill-pushers, afraid of simple procedures. My idiot GP wouldn't even burn a mole off my eyebrow....wanted to send me to a dermatologist! So I bought a bottle of apple cider vinegar and did it myself.....a week of dousing it with the vinegar and covering it wet with a band-aid and it fell off . And I still have the $200 deductible the dermo would have cost me.
JimBowie1958
Old Fogey
- Sep 25, 2011
- 63,590
- 16,901
- 2,220
There is also phage therapy, a promising technique that is cheap and addresses local bacterium.
Phage therapy - Wikipedia, the free encyclopedia
Used under the Soviets, it had about a 50% effectiveness, but the advantage is that it never allowed resistance to develop to it. And more professional implementation could probably do much better than 50%.
waltky
Wise ol' monkey
Chickens source of new MRSA superbug strain..

New Strain of 'Superbug' Traced to Chicken
September 26, 2016 - An international team of scientists has identified a new strain of “superbug” that has made people sick, and it apparently came from chickens.
New Strain of 'Superbug' Traced to Chicken
September 26, 2016 - An international team of scientists has identified a new strain of “superbug” that has made people sick, and it apparently came from chickens.
The new strain of Methicillin-resistant Staphylococcus aureus, better known as MRSA, sickened 10 people in Denmark. Researchers traced the staph bacteria, which is resistant to several antibiotics, and can be fatal, to contaminated poultry people handled or ate. Most people don’t acquire MRSA from chickens or other food animals. It’s usually spread in hospitals, through person-to-person contact, where people live and gather in close quarters in the community. While farm workers are at higher risk of becoming ill with staph infections, the new strain was acquired by city dwellers.

Chickens are seen at a chicken house.
The latest findings, published in the journal Clinical Infectious Diseases, demonstrate that MRSA, which is known to exist in pork, beef and dairy products, can be spread to people through contact with infected animal products. In the study, researchers used genetic analysis to compare the strains of MRSA found in the 10 Danes to staph infection in other people and in livestock. The analysis showed it was exactly the same MRSA strain found in contaminated poultry. The chicken meat was imported from other countries, including France, the Netherlands and Germany. Last week, the United Nations hosted a high level meeting of hundreds of experts on antibiotic resistance to discuss how it will become a global crisis if nothing is done.

An employee displays MRSA (Methicillin-resistant Staphylococcus aureus) bacteria strain inside a petri dish containing agar jelly for bacterial culture in a microbiological laboratory in Berlin.
The participants called for a number of collaborative measures by public and private sectors to ensure the smart use of antibiotics. One of those in attendance was Laura MacCleery, Vice President for Consumer Policy and Mobilization at Consumers Union based in Washington D.C. One of the group’s main concerns is the overuse and misuse of antibiotics in livestock, which can make the drugs ineffective and create superbugs like MRSA. “Animals are routinely given sub-therapeutic doses of antibiotics because the conditions in which they live are unsanitary,” said MacCleery. While the drugs are designed to keep the food animals healthy and promote their growth, the antibiotics, and the bacteria resistant to them, can be passed along the food chain to humans.
The U.S. campaign for the smart use of antibiotics parallels similar efforts in Europe and Canada.
At the U.N. meeting, MacCleery said a number of measures were discussed to reduce antibiotic resistance, not only in animals as a source, but in general. “Drug pricing and availability at a level of provider incentives, those are the kinds of things that governments can do to discourage inappropriate prescribing among physicians, and to educate consumers about the potential risk of antibiotic resistance,” said MacCleery. MacCleery said Consumers Union has been successful in getting a number of fast food chains, including MacDonald’s, to commit to not using chicken that has been treated with antibiotics. Meanwhile, researchers predict there will be a rise in new, more virulent strains of MRSA if antibiotics continue to be used in livestock.
New Strain of 'Superbug' Traced to Chicken
Similar threads
- Replies
- 2
- Views
- 129
- Replies
- 16
- Views
- 254
- Replies
- 44
- Views
- 404
- Replies
- 60
- Views
- 736
New Topics
-
-
-
-
Supreme Court rules mail-in ballots arriving after Election Day can be counted
- Started by Zincwarrior
- Replies: 40
-
Latest Discussions
-
US military says it struck 10 targets in Iran as ceasefire is strained by 2nd day of attacks
- Latest: Admiral Rockwell Tory
-
NYT bombshell: Trump sons cash in on $1.6 billion federal mining deal
- Latest: Zincwarrior
-
